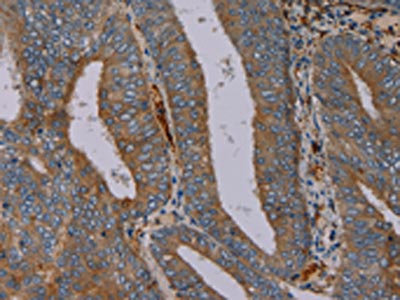

PYY Antibody
-
中文名稱:PYY兔多克隆抗體
-
貨號:CSB-PA056057
-
規格:¥1100
-
圖片:
-
The image on the left is immunohistochemistry of paraffin-embedded Human colon cancer tissue using CSB-PA056057(PYY Antibody) at dilution 1/40, on the right is treated with synthetic peptide. (Original magnification: ×200)
-
The image on the left is immunohistochemistry of paraffin-embedded Human thyroid cancer tissue using CSB-PA056057(PYY Antibody) at dilution 1/40, on the right is treated with synthetic peptide. (Original magnification: ×200)
-
-
其他:
產品詳情
-
Uniprot No.:
-
基因名:
-
別名:GHYY antibody; MGC19143 antibody; Peptide tyrosine tyrosine antibody; peptide YY antibody; Peptide YY like antibody; Peptide YY precursor antibody; Peptide YY(3-36) antibody; Prepro PYY antibody; PYY 1 antibody; PYY antibody; PYY II antibody; PYY-I antibody; PYY-II antibody; PYY_HUMAN antibody; PYY1 antibody; RATGHYY antibody; Yy antibody
-
宿主:Rabbit
-
反應種屬:Human,Mouse,Rat
-
免疫原:Synthetic peptide of Human PYY
-
免疫原種屬:Homo sapiens (Human)
-
標記方式:Non-conjugated
-
抗體亞型:IgG
-
純化方式:Antigen affinity purification
-
濃度:It differs from different batches. Please contact us to confirm it.
-
保存緩沖液:-20°C, pH7.4 PBS, 0.05% NaN3, 40% Glycerol
-
產品提供形式:Liquid
-
應用范圍:ELISA,IHC
-
推薦稀釋比:
Application Recommended Dilution ELISA 1:2000-1:5000 IHC 1:50-1:200 -
Protocols:
-
儲存條件:Upon receipt, store at -20°C or -80°C. Avoid repeated freeze.
-
貨期:Basically, we can dispatch the products out in 1-3 working days after receiving your orders. Delivery time maybe differs from different purchasing way or location, please kindly consult your local distributors for specific delivery time.
-
用途:For Research Use Only. Not for use in diagnostic or therapeutic procedures.
相關產品
靶點詳情
-
功能:This gut peptide inhibits exocrine pancreatic secretion, has a vasoconstrictory action and inhibitis jejunal and colonic mobility.
-
基因功能參考文獻:
- the current review aims to compile, evaluate and summarise current knowledge on PYY, with particular emphasis on obesity and diabetes treatment, and the importance of specific Y receptor interactions for this. PMID: 29412828
- Data show that peptide YY (PYY) mRNA levels were ~ 40,000-fold higher in mouse than human islets, suggesting a more important role of locally secreted Pyy in mouse islets. PMID: 29455414
- Data suggest that dose/intensity-response relationships exist between exercise intensity and total plasma PYY levels, though the effects on total plasma GLP1 levels and hunger perceptions seem unclear. (PYY = peptide YY ; GLP1 = glucagon-like peptide 1) PMID: 27721013
- Data suggest that hunger, pleasantness of eating, and prospective food intake are down-regulated in older women and this is accompanied by up-regulation of blood levels of peptide YY; both age and sex of subject appear to have independent effects on energy intake. This study was conducted in London and is reported as preliminary evidence. PMID: 27264721
- In extremely obese patients, fasting PYY3-36 concentrations were linked to systolic blood pressure, but not to other components of metabolic syndrome, suggesting divergence between pathways of blood pressure and glucose/body weight regulation. PMID: 27513679
- expression of PYY and its NPY receptors on mouse islets and immortalised rodent and human beta-cells was examined. PMID: 27465830
- Altogether, these results demonstrated a role of toll-like receptors in the modulation of Pyy expression and the importance of butyrate, a product of bacterial fermentation in regulation of microbial toll-like receptor-dependent sensing. PMID: 27405092
- Data suggest that laparoscopic sleeve gastrectomy (LSG) for morbid obesity improves insulin resistance after either fast or slow feeding/eating; these findings suggest a negligible contribution of anorexigenic gut peptides GLP1 (glucagon-like peptide 1) and PYY (peptide YY) from intestinal L cells in response to LSG-induced weight loss. PMID: 27022941
- Angiotensin II stimulates PYY secretion, in turn inhibiting epithelial anion fluxes, thereby reducing net fluid secretion into the colonic lumen. PMID: 27447725
- These findings indicate that the mechanism underlying type 2 diabetes remission may be mediated by PYY. PMID: 27117413
- In male GERD patients, EE was associated with significantly higher PYY levels [107.0 (55.0-120.8) vs. 32.8 (28.7-84.5) pg/ml, p = 0.026] but lower adiponectin levels [6.7 (5.6-9.3) vs. 9.9 (9.6-10.6) mug/ml, p = 0.034] than NE PMID: 26506614
- Data suggest that endocrine responses differ between jejunal and gastric enteral feeding, with higher peak plasma CCK (cholecystokinin), PYY (peptide YY), and GLP-1/2 (glucagon-like peptides 1/2) concentrations being attained after jejunal feeding. PMID: 26762368
- Data suggest that capsaicin, an appetite suppressant dietary supplement (here, administered via intraduodenal infusion), does not act via alteration of secretion of satiety hormones PYY (peptide YY) and GLP-1 (GLP-1). PMID: 26718419
- Data suggest that, despite effects of acute sprint interval exercise (SIE) on oxygen consumption, appetite regulation, and brief up-regulation of plasma PYY, acute SIE does not affect energy intake of young men. PMID: 25494974
- Plasma PYY and PP levels were significantly higher in HG [Hyperemesis gravidarum ] group. PMID: 25990478
- Data suggest plasma PYY (peptide YY) and GLP1 (glucagon-like peptide 1) can be regulated by digestion-resistant diet factors; intake of soluble dietary fiber (prebiotic Fibersol-2) in a tea with meal up-regulated plasma PYY/GLP1 and decreased hunger. PMID: 25823991
- Eating speed at breakfast did not affect postprandial ghrelin, GLP-1, PYY, hunger, and fullness values or daily energy and macronutrient intake. PMID: 25361054
- These results indicate that circulating PYY may have buffering effects during the early stages of smoking cessation while ghrelin may confer increased risk of smoking relapse. PMID: 25127083
- Data suggest secretion of PYY and GLP1 (glucagon-like peptide-1) can be altered by diet; plasma levels of PYY/GLP1 are increased during postprandial period after meal using Paleolithic diet principles (high in protein/plant matter; no cereals/dairy). PMID: 25661189
- Intraduodenal lipid more potently stimulated PYY release when compared to intraduodenal protein. PMID: 25568079
- data suggested that peptide YY expression is down-regulated by differentiation of monocytes to macrophages and proinflammatory stimuli. PMID: 24969624
- Although the effect size of the positive association of PYY with obesity in women is small, and potentially negligible, it may in fact represent a protective response against significant weight gain PMID: 24743402
- We critically discuss recent findings relating to the role of PYY in mediating the beneficial effects of bariatric surgery, the role of PYY in glucose homeostasis, the role of hepatoportal PYY in mediating its central physiological effects--{REVIEW} PMID: 24188711
- PYY and ghrelin are reciprocally associated during a period of weight stability, but not following weight loss PMID: 24012997
- PYY3-36 concentrations were suppressed in the women with High cognitive restraint PMID: 23831742
- We aimed to determine whether fasting or meal-stimulated ghrelin, PYY, CCK, and satiety responses are different between lean PCOS patients and healthy women. PMID: 24001751
- glucagon-like peptide 1 and peptide YY colocalize in primary cultured human L cells PMID: 23519462
- Report high densities of serotonin and peptide YY cells in the colon of patients with lymphocytic colitis. PMID: 23155335
- Peptide YY (PYY) is affected in several gastrointestinal diseases and disorders. Changes in PYY appear to be an adaptive response to alterations in pathophysiological conditions caused by the disease. [review] PMID: 23292145
- Data suggest that plasma PYY increases more after high-fat meal rather than after high-carbohydrate meal; plasma PYY is not associated with hunger or fullness; plasma PYY is not associated with energy intake. PMID: 23509106
- These findings underscore the important role of the NPY-Y receptor system at several levels of the gut-brain axis in which opeptide Y, peptide yy and pancreatic polypeptide operate both as neural and endocrine messengers--{REVIEW} PMID: 22979996
- In obese woman during caloric restriction, PPY concentrations (and pancreatic polypeptide) were greatest following liquid high-protein meals compared to high carbohydrate liquid meals. PMID: 23371976
- Circulating concentrations of PYY were inversely associated with circulating concentrations of ghrelin over 24 h in normal weight, premenopausal women. PYY may contribute to the modulation of the secretion of GHR in normal weight, premenopausal women. PMID: 22954902
- Plasma PYY levels increase both in obese adolescents and in obese adults, irrespective of eating rate; slow feeding behavior is more effective in stimulating PYY release/secretion in obese adolescents than in obese adults. PMID: 23239758
- review of evidence linking biosynthesis of peptide YY in strumal carcinoid of the ovary and severe constipation [CASE REPORT; REVIEW] PMID: 22563842
- a lineage of mature enteroendocrine cells have the ability to coexpress members of a group of functionally related peptides: CCK, secretin, GIP, GLP-1, PYY, and neurotensin PMID: 23064014
- Data suggest that patients who report recent weight loss at diagnosis of major depression exhibit high levels of plasma PYY (but not plasma ghrelin or serum brain-derived neurotrophic factor); elevated PYY could contribute to reduced appetite. PMID: 22183081
- PYY is capable of influencing cholesterol homeostasis in intestinal Caco-2/15 cells depending on the site delivery. PMID: 22844422
- Examine changes in fasting total peptide YY (PYY) and ghrelin in nonobese premenopausal women after an exercise and diet program with and without weight loss. Neither fasting ghrelin nor PYY changed in response to exercise in the absence of weight loss. PMID: 21502892
- The R72T variant in PYY gene was not associated with obesity and most of its related anthropometric measurements. This suggests that other genes and/or environmental factors like dietary habits and lifestyle factors may be the contributors of obesity. PMID: 22303574
- PYY(3-36) is also present in murine as well as in human saliva PMID: 22028819
- The sweet taste receptors (alpha-gustducin and T1R3) are involved in glucose-stimulated secretion of GLP-1 and PYY. PMID: 21324568
- These data suggest that ghrelin is a physiological regulator of growth hormone (GH) in the post-oral glucose state, and the decreased ghrelin secretion could be one of the mechanisms responsible for the altered GH secretion in obesity. PMID: 21667426
- Data suggest that hyperphagia in Prader-Willi syndrome is not related to a lower postprandial GLP-1 or PYY response, and that elevated ghrelin levels are consistent with increased hunger and are unrelated to insulin levels. PMID: 21722955
- PYY varies in accordance with energy content and resting metabolism, supporting a role for PYY in energy balance modulation PMID: 21610227
- conclude that the C-terminal helix is crucial for the structural integrity of PYY PMID: 21360523
- higher levels of PYY are associated with disordered eating psychopathology independent of BMI in women across the weight spectrum PMID: 21098684
- postprandial PYY secretion is not affected by glycemic load but is blunted in obese black women compared with normal weight black women and with white women PMID: 19875990
- Several LEP, and NPY2R and PYY SNPs were associated with obesity-related phenotypes in young adults, particularly among African-Americans. PMID: 20642810
- During mid-puberty, at a time when growth hormone levels are the highest, PYY is at a nadir, and these low PYY levels may facilitate pubertal progression and growth PMID: 20375207
顯示更多
收起更多
-
亞細胞定位:Secreted.
-
蛋白家族:NPY family
-
數據庫鏈接:
Most popular with customers
-
-
YWHAB Recombinant Monoclonal Antibody
Applications: ELISA, WB, IHC, IF, FC
Species Reactivity: Human, Mouse, Rat
-
Phospho-YAP1 (S127) Recombinant Monoclonal Antibody
Applications: ELISA, WB, IHC
Species Reactivity: Human
-
-
-
-
-